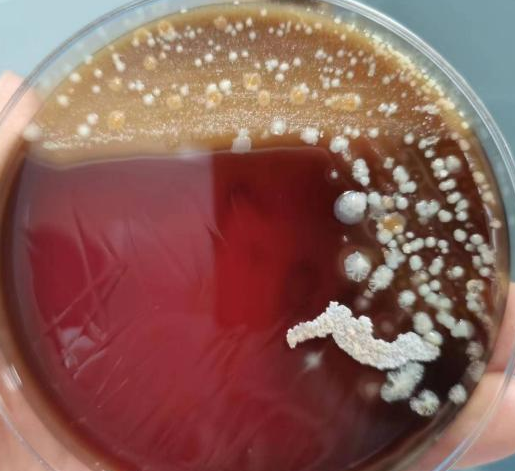
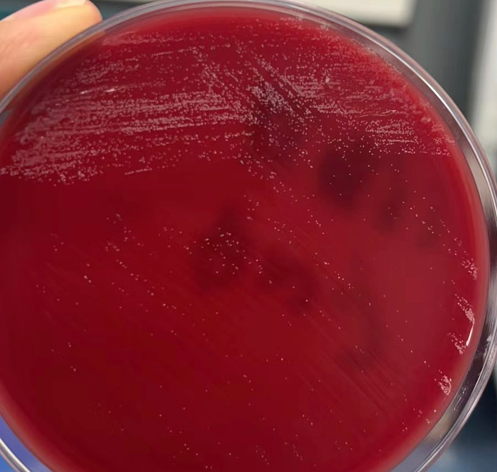
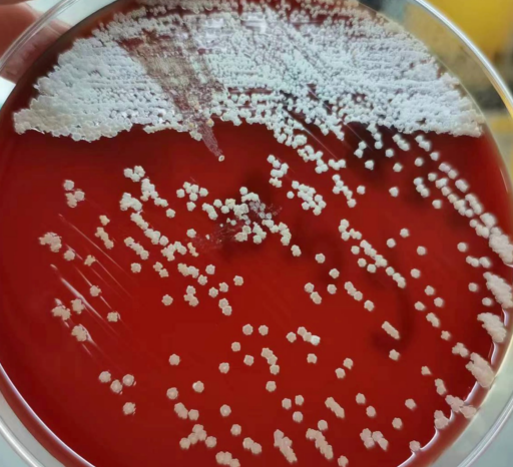

1月10日,山西省医院协会常务理事单位——介休市人民医院在医治一例咳、喘加重致意识障碍患者期间,首次检测出不属于人体正常菌群——诺卡菌。
患者罗某,1月9日23时因“意识障碍4小时”到介休市人民医院急诊科就诊,进行一系列的检查后入住感染性疾病科。入院前,患者间断咳嗽、喘息近半个月,加重4天,初步诊断为电解质紊乱、重症肺炎、高血压3级极高危组、冠状动脉粥样硬化性心脏病、贫血。
主管医生李惠根据检查检验结果,及时申请了痰培养和血培养检验项目。检验科微生物室收到痰培养标本后按照标准操作规程,首先对痰液标本进行涂片染色镜检(革兰染色+抗酸染色),用以判断标本质量并发现可疑病原菌。
微生物组长张秋芳用显微镜对涂片染色结果进行复核时,在镜下发现一团丝状革兰染色,在不能确定此物性质的情况下,将周边伙伴召集在一起。大家轮流去看显微镜中的标本并发表意见:丝状,但和真菌菌丝形状不太一样;杆状,有分枝,但和分枝杆菌也不像,是放线菌吗?心有方向的张秋芳建议加做一个弱抗酸染色。“诺卡菌?!”大家犹疑地说道。(下图为革兰染色涂片镜下形态)。

说干就干,10分钟后,标本弱抗酸染色结果出来了。正如张秋芳所料,镜下形态果然和诺卡菌描述一致。
诺卡菌在自然界分布广泛,多为腐生寄生菌,有51个菌种,对人体致病的主要有三种:星形诺卡菌、巴西诺卡菌和豚鼠诺卡菌。其中星形诺卡菌在我国最常见,致病力最强。所致疾病称为诺卡菌病,常表现为肺部化脓性炎症与坏死,严重者可通过血流播散至全身。
看到结果,张秋芳立即通知患者的主管医生李惠,并和感染性疾病科主任罗孝斌进行沟通,说明诺卡菌培养生长缓慢的特点,2-3天左右才可看到针尖样的菌落,建议临床根据痰涂片结果有针对性地用药,以控制病情。(下图为弱抗酸染色涂片镜下形态。)

标本培养48小时后,检验科人员看到了可疑菌落,又选择典型菌落进行纯培养,24小时后长出了针尖样的小菌落,继续纯培养48小时后,长出白色的“咬琼脂”现象的典型菌落,证实了最初的判断。
经过10天的对症治疗,患者PCT由1.4ng/ml下降到0.15ng/ml,白细胞总数由13.29×10^9/L下降到7.15×10^9/L,中性粒细胞比例由96.3%下降到84.5%,患者临床症状有了较大改善。
▲标本培养48h后血平板现象
▲分纯培养24h后可见“针尖样”
▲分纯培养48h后可见“咬琼脂”
诺卡菌不属于人体正常菌群,因此感染为外源性感染,是一种机会致病菌,免疫力低下的人群易感,可通过皮肤和呼吸道侵入人体,引起急性或慢性化脓性或肉芽肿性疾病,如肺炎、皮下脓肿、脑脓肿、腹膜炎、菌血症等,其中以肺部感染多见。抗菌药物可选用阿米卡星、头孢曲松、复方新诺明、利奈唑胺、亚胺培南等。
经了解,该患者长期收废品,与泥土以及灰尘性物质接触较多,有接触病原菌的环境,加之其身体素质不佳,为感染诺卡菌提供了可能。
专家提醒,诺卡菌病的预防目前无针对性的有效方法,但是可以通过防止发生外伤,对于外伤伤口及时处理,注意消毒,加强个人卫生等方法减低感染的风险。(张惠玲)


